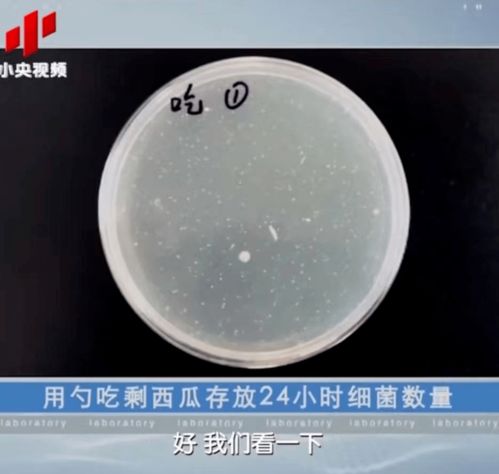
链霉菌

一、从地球到太空,实验对象的特殊使命
随着神舟二十号载人飞船的成功发射,一批特殊的“旅客”也顺利抵达了中国空间站。它们不是普通的乘客,而是肩负重要科研任务的实验对象——斑马鱼、涡虫和链霉菌。这些小小的生物将在太空中展开一系列生命科学实验,为人类探索微重力环境下的生命奥秘提供关键数据。
你知道吗?涡虫是首次登上太空的实验对象!
作为一名对航天科技充满好奇的普通人,我对中国空间站的这次实验充满了期待。通过央视网的消息得知,此次实验将围绕失重性骨丢失、心肌重塑以及微生物在极端环境中的变化展开研究。这不仅有助于揭示太空环境对人体的影响,还可能为未来的深空探测任务提供支持。

中科院空间应用工程与技术中心的研究人员表示,斑马鱼作为高等脊椎动物的代表,能够帮助科学家了解微重力对骨骼和肌肉系统的影响。而涡虫因其强大的再生能力,成为研究修复机制的理想模型。至于链霉菌,则可以帮助我们探索微生物在太空环境中的适应性变化。
二、为什么选择这些实验对象?
或许有人会问,为什么偏偏选择了斑马鱼、涡虫和链霉菌作为实验对象呢?答案其实并不复杂。斑马鱼是一种常见的模式生物,其基因组与人类高度相似,非常适合用于研究骨骼和心血管系统的发育与病变。涡虫则以其惊人的再生能力著称,即使被切成碎片也能重新长出完整的个体。这种特性让科学家们对其在太空环境下的表现格外关注。
至于链霉菌,它不仅是地球上最重要的抗生素生产者之一,还在极端环境中展现出顽强的生命力。通过观察链霉菌在太空中的生长情况,我们可以更好地理解微生物如何应对辐射、失重等不利条件。

赵博生研究员提到,在中国空间站进行涡虫实验的目的,是为了探寻太空复合环境对生物体再生过程的影响。他希望这项研究能够为未来开发新型药物或治疗手段提供理论依据。
三、实验背后的科技支持
当然,要让这些实验对象成功完成任务,离不开先进的技术支持。据北青网报道,神舟二十号乘组的主要职责包括保障系统运行、执行各项任务,并确保实验顺利开展。他们将在为期约6个月的驻留期间,密切监控实验进展并采集相关数据。
为了保证实验设备正常运转,科研团队设计了一套精密的实验单元。这套单元不仅可以模拟地球上的实验环境,还能实时记录实验对象的状态变化。此外,通过上行近2吨科学物资,研究人员为实验提供了充足的保障。
值得一提的是,这次实验还利用了人工智能技术进行数据分析。例如,百度最新发布的文心大模型4.5就有可能应用于实验数据的处理与解读中。虽然具体合作细节尚未公布,但可以预见的是,AI技术将成为未来航天科研的重要助力。
四、展望未来:太空实验的意义
从“太空养鱼”到涡虫再生研究,每一次实验都让我们离揭开宇宙奥秘更近一步。通过这些实验,我们不仅能更好地了解生命在极端环境下的适应机制,还能为未来的星际旅行奠定基础。
想象一下,如果有一天人类真的能够实现星际移民,那么今天在空间站中进行的每一项实验,都将成为通向未来的基石。正如黑龙江日报所言,涡虫的生命历程已经超过5.2亿年,而它的太空之旅或许将开启一段全新的篇章。
最后,我想引用一句名言:“科学的道路没有尽头。”正是这种不断探索的精神,推动着我们一步步走向未知的世界。




发表评论 取消回复